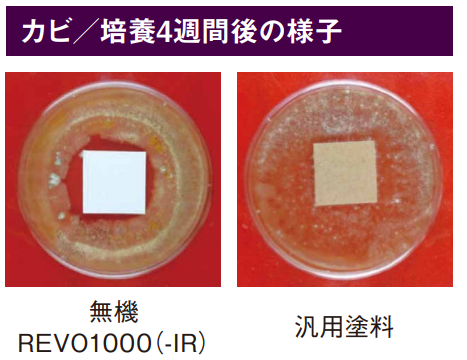
テキスト

AI 生成コンテンツは誤りを含む可能性があります。
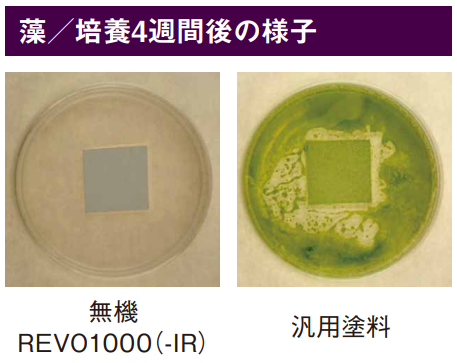
図形 が含まれている画像

AI 生成コンテンツは誤りを含む可能性があります。

【ついに無機グレードが登場】「無機REVO1000(-IR)」の特徴を徹底解説


近年の建築塗装市場では、高耐久無機塗料の需要が拡大しています。このたびアステックペイントでは、多くの加盟店の皆様からご好評いただいているREVOシリーズの無機グレードとなる「無機REVO1000(-IR)」を2026年3月に発売いたしました。
今回の記事では、これまでのREVOシリーズの性能を維持しつつ、20~22年の期待耐用年数を発揮する「無機REVO1000(-IR)」について詳しく解説いたします。取り扱い希望の方はぜひ記事下フォームからもお問合せください。
無機REVO1000(-IR)の特長

無機REVO1000(-IR)は、無機塗料ならではの「高耐候性」を発揮しつつ、その他REVOシリーズと同等の「遮熱性」「低汚染性」「可とう性」をバランスよく兼ね備えています。

【無機REVO1000(-IR)の機能一覧】
| 特長 | 概要 |
| 高耐候性 | ・HALS含有 有機無機ハイブリッド樹脂の採用 ・ラジカル制御型白色顔料の採用 |
| 遮熱性 ※IRのみ | ・近赤外線を反射しやすい特殊遮熱無機顔料の採用 |
| 可とう性 | ・無機塗料ながら180℃曲げても割れなし |
| 低汚染性 | ・表面が強靭な層で作られた樹脂により汚れが付着しにくい ・カビ・藻の発生を抑え、美観の維持に貢献 |
【無機REVO1000(-IR)の種類】
| 無機REVO1000-IR | 無機REVO1000 |
| 遮熱タイプ(-IR) | 通常タイプ(非遮熱) |
| 艶:艶有・3分艶・艶消 | 艶:艶有・3分艶・艶消 |
| 色:アステック標準色69色※一部の色で近似色対応となっています。 | 色:アステック標準色69色※一部の色で近似色対応となっています。 |
高耐候性
無機REVO1000(-IR)は「HALS含有 有機無機ハイブリッド樹脂」と「ラジカル制御型白色顔料」によって高い耐候性を発揮しています。
【促進耐候性試験の試験結果】
無機REVO1000(-IR)は、促進耐候性試験※1(キセノンランプ式)において、8000時間経過後も「光沢保持率80%以上」を保持しています。
※1:自然環境のデータをもとに人工的に強烈な紫外線、熱、水などの負荷をかけることで、短い期間で長期間を経過させた塗膜の表面状態を再現することができる試験のこと。

| 【高耐候性を発揮する理由① ~HALS含有 有機無機ハイブリッド樹脂の採用~】 |
| 無機REVO1000(-IR)が高い耐候性を発揮する理由の一つは、樹脂にあります。 本製品に採用した「HALS含有 有機無機ハイブリッド樹脂」は、結合エネルギーが高く紫外線などに強い“無機成分の核”を、HALS※2を含む“有機成分”が覆う構造をしています。 一般的に、無機成分は劣化しにくい一方で、有機成分は紫外線などで劣化しやすい性質があります。しかし本製品では、有機成分に配合したHALSが劣化の原因となるラジカル※3を捕捉し、有機成分の劣化を抑制します。 この「劣化に強い無機成分」と「HALSで劣化を抑えた有機成分」の組み合わせにより、高い耐候性を実現しています。 ※2:Hindered Amine Light Stabilizerの略称で光安定剤とも呼ばれる。塗料に添加または結合させることにより、塗膜の劣化の要因となるラジカルを捕捉して、塗膜の耐候性を向上させる。 ※3:白色顔料や樹脂に紫外線が照射された際などに発生する、有機物(樹脂など)を分解するエネルギーのこと。塗膜表面でラジカルが発生すると、樹脂などの有機物が破壊され、塗膜表面のチョーキング劣化が進行してしまう。  |
| 【高耐候性を発揮する理由② ~ラジカル制御型白色顔料の採用~】 |
| 塗料は、複数の顔料を適切な比率で組み合わせることで、多様な色を表現します。 (例:紫系 = 青系顔料 + 赤系顔料) 顔料には様々な種類・色がありますが、その中でも白色顔料として一般的に用いられているのが「酸化チタン」です。酸化チタンは「下地の色の隠蔽性」に優れていますが、紫外線が当たることで塗膜の劣化要因となる「ラジカル」を発生させてしまう性質があります。 無機REVO1000(-IR)は、「ラジカル制御型白色顔料」という、酸化チタン表面にシールド層を形成することでラジカルの放出を抑制する特殊な白色顔料を採用しています。これにより、塗膜の劣化要因の発生を抑え、樹脂本来の耐候性を十分に発揮できます。  |
遮熱性
無機REVO1000-IRでは、日射反射率が高い遮熱顔料を採用しています。特に、一般的な黒色顔料よりも熱を吸収しにくい「特殊遮熱無機顔料※4(黒色)」で調色することで濃色系の色でも高い遮熱性を発揮しています。
※4:調色で用いられる顔料には様々な種類があり、大きく、「有機顔料」と「無機顔料」に分けられている。それぞれの特長は以下の通りである。
・有機顔料:石油から構成される合成顔料であり、鮮やかな色・豊富な色を出せる。
一般的に無機顔料よりも紫外線で劣化しやすい傾向がある。
・無機顔料:天然鉱石や金属などから作られる顔料のことであり、紫外線で劣化しにくい。
一般的に有機顔料よりも、鮮やかさ、色数に欠ける傾向がある。
【特殊遮熱無機顔料の特長① 日射反射率が高い】
遮熱性を持たない一般的な塗料では、黒色顔料にカーボンブラックや酸化鉄といった近赤外線を吸収しやすい無機顔料が使用されています。特に黒色顔料は、熱源である近赤外線を吸収しやすいため、温度が上昇しやすい傾向があります。
一方、無機REVO1000-IRで採用されている黒色の特殊遮熱無機顔料は、従来の黒色顔料よりも近赤外線の反射率が高く、塗膜表面の温度上昇を抑えることができます。

【特殊遮熱無機顔料の特長② 遮熱顔料でありながら紫外線に強い】

一般的な遮熱顔料は有機顔料の混色で黒色を作ることがあり、紫外線によって顔料が劣化し、退色の原因となりやすいです。
しかし、無機REVO1000-IRでは「黒色の特殊遮熱無機顔料」を採用することで、遮熱塗料でありながらも紫外線による影響を受けにくく、「退色しにくい」という特長を持っています。
【無機REVO1000-IRの日射反射率の試験データ】
無機REVO1000-IRでは日射反射率試験を実施し、以下のような試験結果を得ています。
・無機REVO1000-IR(色:N-60) 日射反射率:63.4%
可とう性
一般的に、無機塗料は硬く強固な塗膜を形成するため、柔軟性が低いという課題があると言われています。無機REVO1000(-IR)は有機無機ハイブリッド樹脂の採用により、無機塗料でありながら柔軟性のある塗膜を形成します。
●可とう性試験結果

低汚染性
無機REVO1000(-IR)は、強靭な塗膜形成による汚れの付きにくさと、防カビ防藻機能によって建物の美観維持に貢献してくれます。


●雨筋曝露試験
無機REVO1000(-IR)と他社塗料を塗装した板を屋外に設置し、経過観察を行いました。
6か月経過時点で、無機REVO1000(-IR)は他社水性一液無機塗料と比べ、雨筋汚染が目立ちにくいことが確認されました。

●かび/藻抵抗性試験
無機REVO1000(-IR)は、「JIS Z 2911かび抵抗性試験方法(社内試験規格)」及び「藻抵抗性試験(社内試験による)」に合格しており、カビ・藻の発生を抑えることで建物の美観維持に貢献できます。

対応素材
無機REVO1000(-IR)は窯業系/金属サイディング、ALC、モルタル外壁など、幅広い用途にご使用いただけます。

製品データ・施工仕様
【製品データ】
◯荷姿:15kg、4kg
◯塗布量:0.25~0.35kg/㎡
◯希釈:ローラーの場合:0~5%(清水)、エアレスの場合:5~10%(清水)
◯艶…艶有、3分艶、艶消
◯色…アステック標準色69色 ※一部の色で近似色対応となっています。
【対応下塗材】
※2026年2月現在
〇水性
・エポパワーシーラー・プレミアムSSシーラープライマー・ホワイトフィラーAⅡ・エピテックフィラーAEⅡ 等
〇弱溶剤
・サーモテックシーラー・エポプレミアムシーラープライマーJY・エポパワーメタルJY・フッ素鋼板用パワープライマーJY・リベット 等
下地調整方法・施工上の注意
【下地調整】
・劣化し脆弱な部分及び錆等は、ディスクサンダー、スクレーパー等により除去してください。
・漏水箇所は予め水が浸入しないように処置し、汚れ、付着物、油脂類等を高圧洗浄、スクレーパーやシンナー等で除去してください。
・塗装する下地は、清浄かつ、十分に乾燥させてください。
・劣化したシーリング材は全て撤去し、新規シーリング材で打ち替えてください。
【施工上の注意】
・雨・強風・結露等の悪天候及びこれらが予想される場合には施工は避けてください。
・5℃以下、湿度85%以上での施工は避けてください。
・使用する前に塗料を十分に撹拌してください。
・ウールローラー施工の場合、塗回数が増えることがありますのでご注意ください。
・エアレス施工の場合には塗装ロスが大きくなりますので、塗布量の上限値を目安にしてください。
・上記塗布量及び塗回数は下地の材質・状態等で増える場合があります。
・シーリング材目地に塗装した場合、動きに追従出来ずに塗膜がひび割れることがあります。
・塗り継ぎや補修塗り(タッチアップ)を行う場合は、ローラー又はエアレス等の塗装方法や希釈率の違いにより、色相差・艶ムラが生じることがありますので、作業後に仕上りをご確認ください。
・トタン板の継ぎ目、折り曲げ部分は、塗膜が薄くなりがちですので、先に拾い塗りをすることをお勧めします。
まとめ
今回は、水性一液無機塗料の無機REVO1000(-IR)をご紹介しました。ご好評いただいているREVOシリーズの性能(遮熱性・低汚染性・可とう性・作業性等)を維持しつつ無機塗料としての高い耐候性を発揮する製品となっております。
無機塗料をご検討の際は、本記事の情報が参考になれば幸いです。


この記事の監修者と運営者

【記事監修】
株式会社アステックペイント
谷口 智弘
【記事監修】
株式会社アステックペイント
谷口 智弘
株式会社アステックペイント技術開発本部 本部長
住宅用塗料市場のマーケティング分析・品質管理を行う「商品企画管理室」、塗料の研究・開発を行う「技術開発部」、塗料の製造・生産・出荷を行う「生産部」の3事業部を統括するマネジャーとして、高付加価値塗料の研究・開発を行っている。

【運営会社】
株式会社アステックペイント
【運営会社】
株式会社アステックペイント
AP ONLINEを運営する株式会社アステックペイントは、建築用塗料を製造・販売する塗料メーカー。遮熱性、低汚染性に優れた高付加価値塗料の研究・開発の他、システム・販促支援など、塗装業界の課題解決につながる事業を展開。2020年以降、遮熱塗料国内メーカーシェアNo.1を連続獲得中。
この記事を読んだ人におすすめの記事
-

-

APラインナップ 2023.1.20
-









